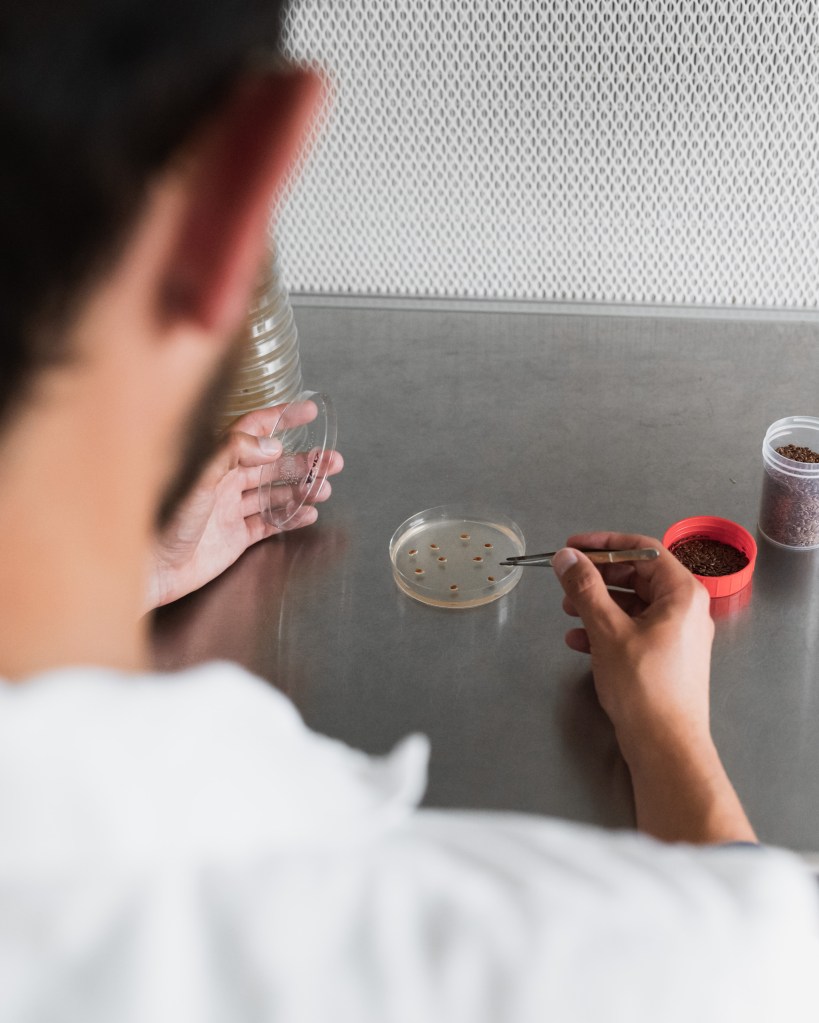

Bienvenue sur la page de Linéa Semences !
La création :
Créé en 2001, Linéa Semences est un obtenteur de variétés de lin localisé en Picardie mais qui sélectionne ses variétés dans toute la zone de production linière française grâce à son réseau d’essais dans de nombreux terroirs.

Recherche & Développement
Linéa semences est spécialisée dans l’innovation et la recherche de nouvelles variétés.
Depuis 2010, Linéa travaille en partenariat avec L’Université de Picardie Jules Verne d’Amiens pour améliorer l’efficacité de ses programmes de sélection en y intégrant les outils de recherche moléculaires les plus pointus et travailler sur les connaissances des maladies du lin.

Ses 4 actionnaires sont présents dans 4 départements liniers et lui permettent d’être présent dans des nombreuses régions :
La coopérative Agylin (Yvetot – 76)
La coopérative du Neubourg (Neubourg -27)
La coopérative Calira (Martainneville – 80)
La coopérative Lin2000 (Grandvilliers 60)
Les Différents Moments De La Floraison

La graine germe, puis la plante s’élève, développant tige et feuilles.

Chaque matin, des fleurs bleues, blanches ou violettes s’ouvrent, ne durant qu’un jour.

Des personnes inspectent les rangées, éliminant les plantes non conformes.
La floraison peut durer plusieurs semaines grâce à une succession de fleurs. Après la chute des pétales, des capsules se forment pour protéger les graines en maturation, concluant ainsi le cycle floral. Ce processus démontre la beauté et la complexité du développement de la fleur de lin, chaque étape étant essentielle à la survie de la variété.
